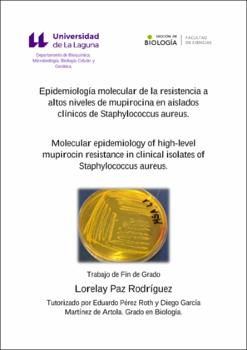
Thumbnail

Epidemiología molecular de la resistencia a altos niveles de mupirocina en aislados clínicos de Staphylococcus aureus
Author
Paz Rodríguez, LorelayDate
2019Abstract
La mupirocina es un antibiótico empleado en el tratamiento de infecciones de la
piel causadas por los estafilococos, y juega un papel clave en el control de portadores
nasales de Staphylococcus aureus resistente a meticilina (SARM). Sin embargo, la
resistencia a altos niveles de mupirocina (Hi-MupR
) se ha asociado al fracaso
terapéutico. El gen ileS2, responsable de la Hi-MupR
, se ubica generalmente en
plásmidos capaces de transferirse horizontalmente entre bacterias. Habitualmente, éstos
son portadores de otros genes de resistencia a antibióticos, y pueden ser adquiridos por
clones epidémicos con gran capacidad de expansión. Así, tanto la diseminación clonal
como la transferencia génica horizontal pueden contribuir en la dispersión de la HiMupR
. El principal objetivo de este estudio fue conocer cómo se dispersa la Hi-MupR
en
una población de S. aureus en 2018 y su asociación con otras resistencias. Para ello, se
realizó la caracterización y tipificación molecular de una muestra de aislados clínicos, y
se inició el estudio de los elementos genéticos portadores del gen ileS2. Esto permitió
concluir que tanto la diseminación clonal como la transferencia génica horizontal
parecen haber contribuido al surgimiento y dispersión de la Hi-MupR
en S. aureus. Mupirocin is an antibiotic used in the treatment of skin infections caused by
staphylococci, and plays a key role in the control of nasal carriers of methicillinresistant Staphylococcus aureus (MRSA). However, high-level mupirocin resistance
(Hi-MupR
) has been associated with therapeutic failure. The ileS2 gene, responsible for
Hi-MupR
, is generally located on plasmids capable of transferring horizontally between
bacteria. Typically, these are carriers of other antibiotic resistance genes, and can be
acquired by epidemic clones with great expandability. Thus, both clonal dissemination
and horizontal gene transfer can contribute to the dispersion of Hi-MupR
. The main
objective of this study was to know how Hi-MupR
is dispersed in a population of S.
aureus in 2018 and its association with other resistances. To do this, the characterization
and molecular typing of a sample of clinical isolates was performed, as well as the
preliminary study of ileS2-carrying elements. This allowed us to conclude that both
clonal dissemination and horizontal gene transfer appear to have contributed to the
emergence and dispersion of Hi-MupR
in S. aureus.